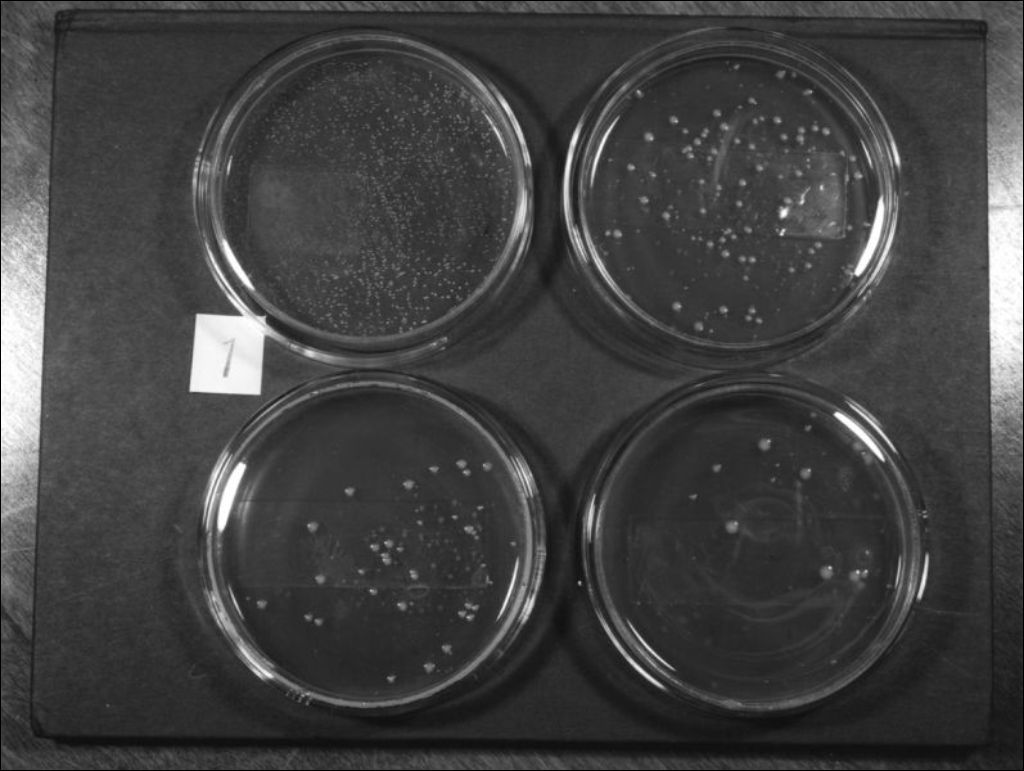

École de laiterie. Ministère de l'Agriculture
Voir les informations
Détails du document
Informations détaillées
- Conditions générales d'utilisation :
-

- Titre :
- École de laiterie. Ministère de l'Agriculture
- Créateur :
- Jacques Desjardins
- Date de création :
- Juillet 1947
- Genre spécifique :
-
- Photographies
-
- Dossier portant sur les étapes du développement de cultures lactiques sur plaquettes et produit pour l'École de laiterie de Saint-Hyacinthe et le ministère de l'Agriculture. Nous observons l'apparition de différentes bactéries à la surface des plaquettes
-
- Dossier portant sur les étapes du développement de cultures lactiques sur plaquettes et produit pour l'École de laiterie de Saint-Hyacinthe et le ministère de l'Agriculture. Nous observons l'apparition de différentes bactéries à la surface des plaquettes
- Sujets traités :
- Notice détaillée :
- Collections et fonds :
- Lieu de conservation :
-
- Archives nationales à Montréal
-
Lien :Le lien est la meilleure manière de partager ou de conserver une ressource. Il est basé sur l'ARK (Archival Resource Key), un identifiant pérenne. Seules les suppressions et les nouvelles numérisations pourraient rendre ce lien invalide.
-
Fichiers (6)
Téléchargement en lot
Vous devez accepter les conditions d'utilisation afin d'accéder au téléchargement en lots.
BAnQ encourage et permet l'utilisation des Contenus sous réserve du respect du droit d'auteur, de tout autre droit pouvant exister et des conditions générales d'utilisation.
BAnQ a recours à des déclarations de droits du consortium RightsStatements.org et à des licences 4.0 de l'organisation Creative Commons. Les Contenus qui sont identifiés à l'aide d'une mention de droits ou d'une licence peuvent être utilisés selon les conditions spécifiques de cette mention ou de cette licence. Consulter le panneau information pour les droits qui s'appliquent sur ce lot.
Lors de toute utilisation permise des Contenus, l'usager doit mentionner le nom de l'auteur ou du créateur (s'il est connu) et mentionner la source (« Bibliothèque et Archives nationales du Québec »), préférablement avec la cote, le numéro d'identification ou l'URL des Contenus utilisés.
Vous pouvez télécharger un maximum de 50 fichiers à la fois.

Références
RIS ou Zotero
EnregistrerEndNote
Enregistrer
Ce document ne peut être affiché par le visualiseur. Vous devez le télécharger pour le voir.
Document disponible pour consultation sur les postes informatiques sécurisés dans les édifices de BAnQ. À la Grande Bibliothèque, présentez-vous dans l'espace de la Bibliothèque nationale, au niveau 1.